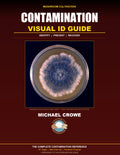
Contamination Visual ID Guide

Skip to product information


Contamination Visual ID Guide
$27.00
Complete protocol for identifying, containing, and responding to contamination events in mushroom cultivation. Includes visual ID guide, investigation checklists, corrective action plans, and prevention strategies. Instant PDF download.